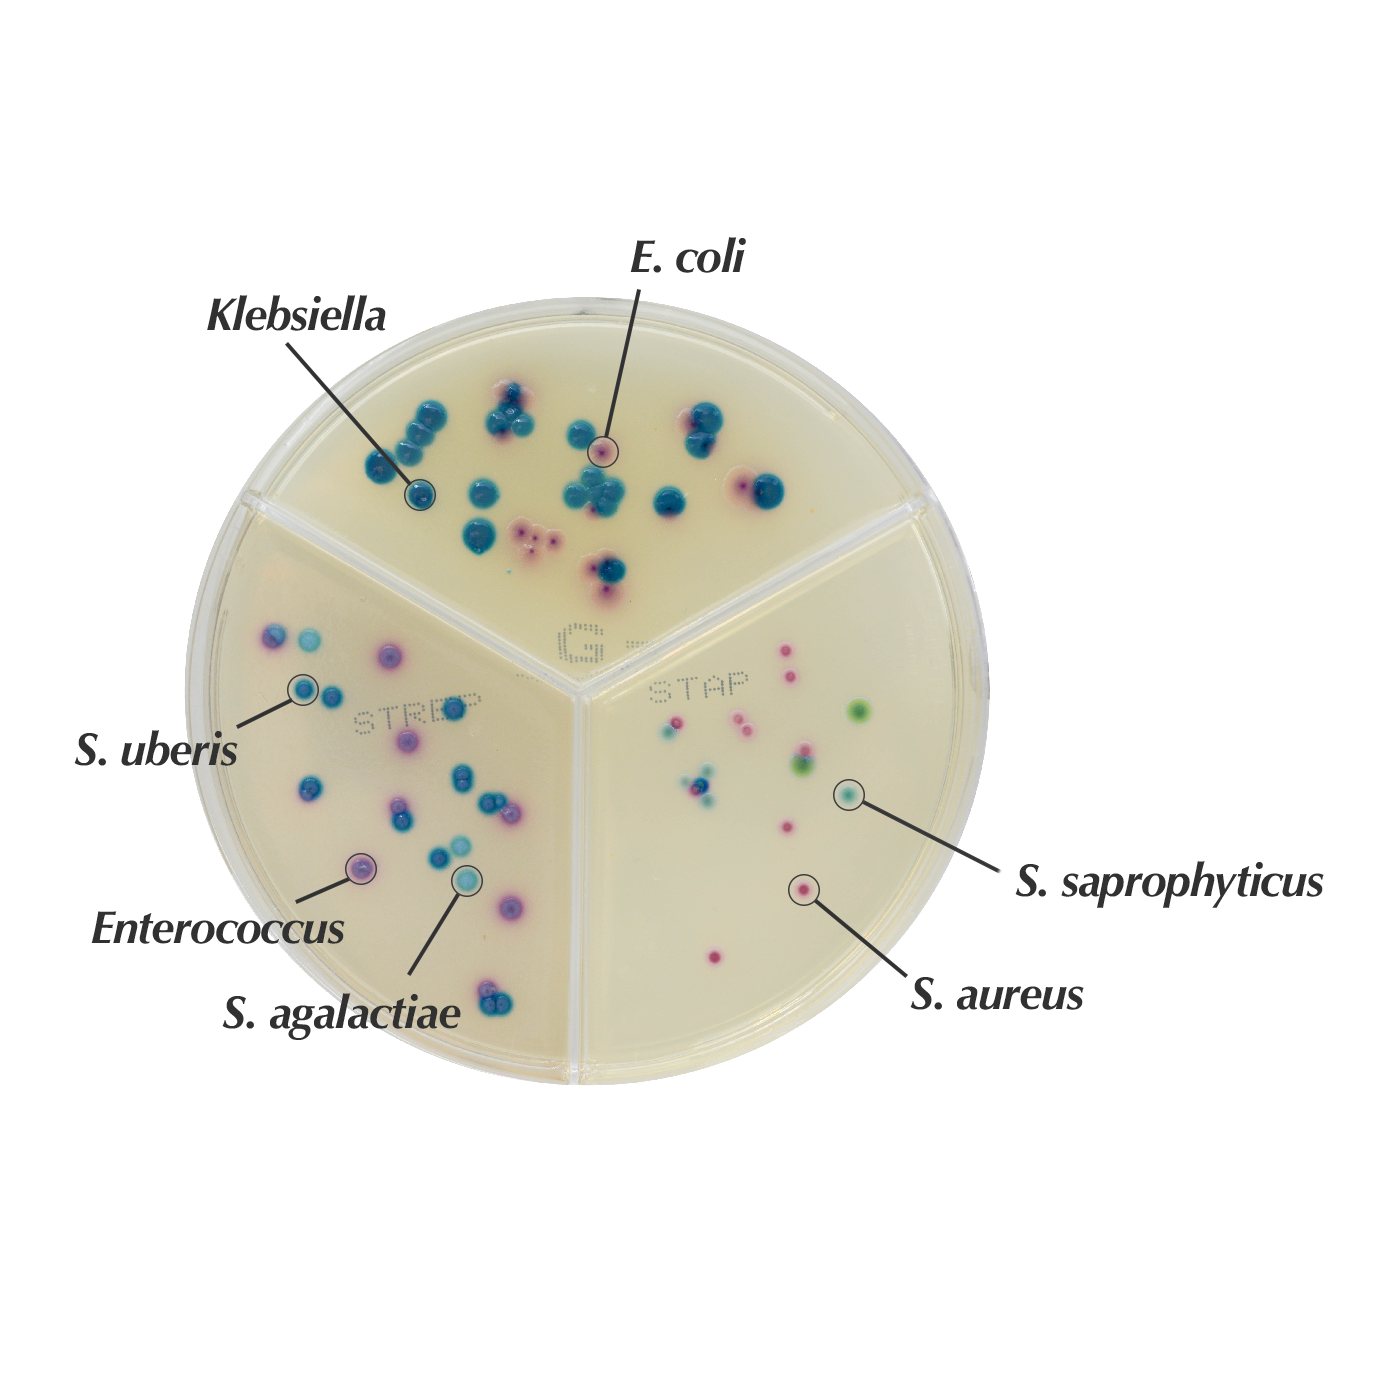
3-sector plate

Colonies Appearance
S. aureus
Pink to mauve
S. epidermidis
Colourless to pinkish
S. saprophyticus
Turquoise blue
Performance
Performance
Combining the performances of our technology, this three-sectors plate contains CHROMagar™ Staphylococcus, CHROMagar™ Streptococcus and CHROMagar™ Mastitis GN.
With the high specificity of the three CHROMagar™ media, this tool allows a very wide differentiation spectrum of microorganisms, particularly interesting in complex matrices like milk from Mastitis cases or animal forensic samples.
Pre-poured plates are now available in several countries in Europe, USA and Brazil. Ask your local distributor for more information.
Composition

Technical Documents
Scientific Publications
2023
Zoonotic Staphylococcus spp. among domestic animals in Ukraine: antibiotic resistance and diagnostic approaches
? Publication2021
Evaluation of Chromogenic culture media for rapid identification of gram-positive bacteria causing mastitis
? Publication2016
Evaluation of an On-Farm Culture System (Accumast) for Fast Identification of Milk Pathogens Associated with Clinical Mastitis in Dairy Cows
? Publication
Read more